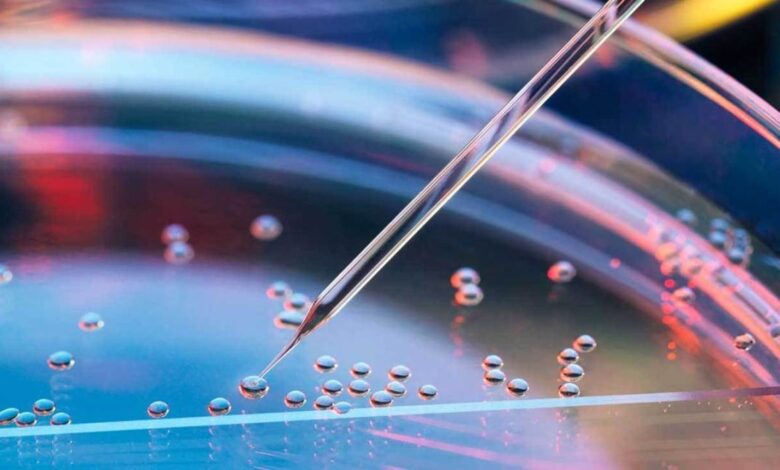

2020年,大多数员工不得不面对双头龙。我们不仅切换到远程工作。我们必须在一家没有足够能力进行如此快速过渡的公司中做到这一点。
这并非易事,尤其是在保持生产率水平的同时:我们当中很少有人有足够的时间去适应新的习惯。但是,您最好遵循几条建议,以使远程工作尽可能有效。
这是每个人都应遵循的七个技巧。
1.在线转移每项与工作相关的活动
每一个,我们的意思是每个。假设您经常在早上与同事闲聊时首先在饮水机周围闲逛。通过在视频电话会议上共享一杯咖啡来重复练习。而且不要害羞:现在在早上聚会上,在镜头前准备吐司已经很重要了。
例行会议也是如此。每天上午10点起床可以转用基于Slack的漫游器,不仅可以使对话简洁明了,还可以使信息保持联机状态以备将来参考。每个场合都有一个工具。发挥创造力,您的虚拟办公室将像以往一样自然。
2.分享您的当前状态
当您进行远程工作时,即使您的同事不想在您的办公桌旁弹出,您仍然需要知道您的忙碌情况。如果您很忙,请屏蔽日历或更妙的是,将“闲置”状态设置为当前活动:“离开”,“正在开会”,“通话中”。
这样做可以使人们知道他们什么时候可以与您联系,或者您可能会被占用多长时间。
3.找到一种保持同步的方式
您的松弛状态显示您当前正在做什么。但是最好也让队友知道你做了什么。为此,您可以在每天结束时在Slack上分享一则帖子,详细说明您在过去八个小时内所取得的成就,并帮助所有人保持一致。
4.将个人通讯放入文档中
通过较少的对话,知识在企业中转移的机会就更少了。因此,至关重要的是,您必须找到一个在线存储库来记录与过去,现在和将来的项目有关的所有信息(严重的是,这是另一个时刻)。
根据经验:您希望能够通过与提供完整上下文的文档的链接来回答每个与项目相关的问题。
5.总是假设没人知道
我们这里的意思是,不要仅仅认为某人掌握了一条信息(如果这样做,则可能会造成巨大的通信故障)。取而代之的是,在您说的每句话中都保持清晰,将上下文与每个内容进行中继。
换句话说,永远不要简单地说“准备好了。”取而代之的是,想想什么信息可以帮助任何阅读该消息的人通过说“我刚刚完成了{project_name}的PPT卡片组”来理解上下文。您可以在GDrive上找到它(这里是链接)。’
6.…而且总是过度沟通
您可以将其称为5.1…,但是我们认为这一点非常重要(并且细微差别),值得我们关注。通过过度沟通,我们的意思是说的话题要比您认为必要的要多(与第5点不同,所有主题都是清楚地进行沟通)。
如果您正在处理任务,请为其分配优先级,谈论您计划做的事情,根据需要经常向其他人寻求帮助,并记录进度,以避免信息流失。
7.拥有单一真理
不要让信息在几个地方出现问题。选择一个任务管理工具,并在其中存储所有与项目相关的信息(包括受让人,任务描述,状态,到源资料的链接等)。
有许多应用程序可以提供此级别的360度覆盖范围-确定哪个最适合您。